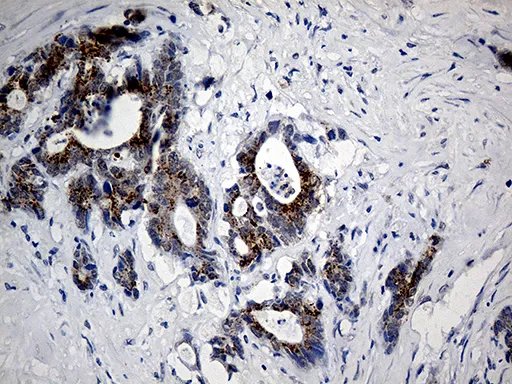

中文 | English

English
C9orf43 mouse monoclonal antibody,clone OTI2G6
货号: GAM922006
C9orf43 mouse monoclonal antibody,clone OTI2G6
反应种属:
Human
应用:
IHCWB
¥ 960
/ 50μl
库存充足
50μl100μl
产品详情
推荐稀释比
产品特性
反应种属
Human
应用
IHCWB
纯化方式
Affinity Purification
克隆号
OTI2G6
免疫源
Full length human recombinant protein of human C9ORF43 (NP_689999) produced in E.coli.
来源
Mouse
克隆性
Monoclonal
预测分子量
52 kDa
Uniprot
Q8TAL5
Isotype
IgG2b
产品别名
C9orf43

货号: GAM922006
C9orf43 mouse monoclonal antibody,clone OTI2G6
反应种属:
Human
应用:
IHCWB
¥ 960
/ 50μl
库存充足
50μl100μl
产品详情
推荐稀释比
产品特性
反应种属
Human
应用
IHCWB
纯化方式
Affinity Purification
克隆号
OTI2G6
免疫源
Full length human recombinant protein of human C9ORF43 (NP_689999) produced in E.coli.
来源
Mouse
克隆性
Monoclonal
预测分子量
52 kDa
Uniprot
Q8TAL5
Isotype
IgG2b
产品别名
C9orf43

扫码添加微信客服
